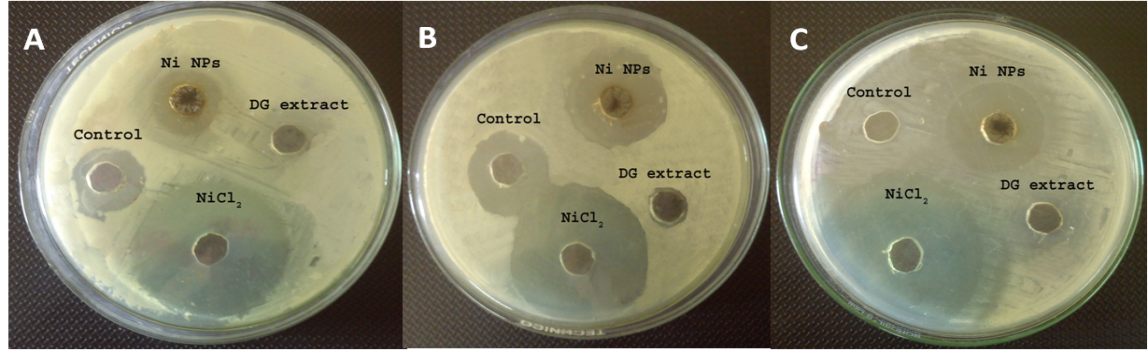

Int J Pharm Pharm Sci, Vol 7, Issue 4, 141-146Original Article
DESMODIUM GANGETICUM ROOT AQUEOUS EXTRACT MEDIATED SYNTHESIS OF NI NANOPARTICLE AND ITS BIOLOGICAL EVALUATION
SUDHASREE S, VAISHALI KRISHNA DOSS, SHAKILA BANU A, GINO A KURIAN*
Vascular Biology Laboratory, School of Chemical and Biotechnology, SASTRA University, Thanjavur, Tamil Nadu.
Email: ginokurian@hotmail.com
Received: 07 Nov 2014 Revised and Accepted: 05 Dec 2014
ABSTRACT
Objective: A novel, eco-friendly method of Nickel nanoparticles synthesis using aqueous extract of Desmodium gangeticum root (DG) has been reported in this study.
Methods: Novel approach on synthesis of Ni nanoparticles using NiCl2 as precursor and aqueous extract of Desmodium gangeticum root as the reducing agent. Nanoparticles were characterized for its average size, morphology, functional moieties and thermal stability by UV-Visible spectrophotometry, X-Ray Diffractometry (XRD), Scanning Electron Microscopy (SEM), Fourier Transform Infrared spectroscopy (FTIR) and Thermo Gravimetric Analysis (TGA) respectively. Cytotoxicity was also determined against LLC PK1 cell lines using LDH assay.
Results: Less aggregate spherical shaped and mono-dispersed nanoparticles were synthesised whose size ranges from 20-30 nm in diameter. Nanoparticles were exhibit face centre cubic crystalline phase with an average size of ~23 nm which was obtained from XRD spectral pattern. Strong interaction between Desmodium gangeticum and nanoparticles was shown in TGA-thermogram. The reducing potential and total phenolic content of Ni nanoparticles was found to be same as that of Desmodium gangeticum. All the results were expressed as mean±SD of n = 4-6 independent assays, p<0.05, whose data were analysed using ANOVA.
Conclusion: Biological activity of the nanoparticles and its toxicity was assessed and found to possess the good antioxidant and reduction potential with significant antibacterial activity and were nontoxic.
Keywords: Green synthesis, Desmodium gangeticum, Ni Nanoparticles, Antimicrobial, DPPH, LLC PK1.
INTRODUCTION
Metal and Metal oxide nanoparticles are now becoming an active area of research especially in the field of regenerative medicine and drug delivery [1]. Ni and its oxide nanoparticles find its significant application in various research areas such as consumer products (batteries and electronics) [2], medical imaging [3], catalysis [4], magnetic storage [5], sensors [6], magnetic ink printing [7] and ferrofluidics [8]. In recent times, Ni nanoparticles have attracted researchers attention due to its high magnetic potential, high magnetoresistance, large coercivities and high Curie temperature.
Ni nanoparticles were synthesized using different approaches such as metal evaporation-condensation [9], electrochemical methods [10], metal salt reduction [11], ultrasound irradiation [12], ultrasound spray pyrolysis [13], polyol methods [14] and neutral organometallic precursor decomposition [15]. Ni nanoparticles can be prepared in various shapes such as nanotubes [16], nano wires [17], nanorods, hollow spheres [18]and nanobelts [19.] In spite of its high yield and better efficiency obtained in conventional synthesis techniques, it has certain limits in terms of toxicity, time consumption, reliability and processing cost. An alternative approach to overcome these limitations is green synthesis involving the exploitation of reducing potential of biomolecules from plants, fungi and bacteria which pave the way for simplicity, economical, less toxicity and feasibility.
The main concern in the synthesis of green nanoparticle is the use of reducing agent like NaBH4 [20] and N2H4, which are mainly involved in the chemical synthesis of nickel nanoparticles. All of these are highly reactive chemicals and pose potential environmental and biological risks. Here, the reducing property of aqueous extract of DG has been exploited for the biosynthesis of nanoparticles.
Desmodium gangeticum (DG) from the Fabaceae family is found mainly in India, China, Africa and Australia. DG has very good medicinal values and thus being used in the Indian system of medicines since ancient times [22]. Desmodium gangeticum with properties like anti-inflammatory [23], anti-analgesic [24] and antioxidant activity [25]. It is found to be very effective against numerous disease conditions viz., jaundice, rheumatism, puerperal fever, paralysis, edema, filaria [26], ischemia reperfusion injury [27] and myocardial infarction [28]. Flavonoids, alkaloids and polyphenol compounds in plants plays a vital role in the preparation of nanoparticles due to its high reducing potential [29]. Pterocarpeniods, gangetin and desmodin, are the major chemical constituents of the Desmodium gangeticum root [30].
MATERIALS AND METHODS
NiCl2, DPPH, Folin-Ciocalteu reagent, Na2CO3, K3 [Fe(CN)6], TCA (TriChloro Acetic acid) and ethanol were purchased from Sigma Aldrich, India. Muller Hinton agar and agar were purchased from HiMedia, India. LLC PK1 cell line was ordered from NCCS, Pune, India. All the chemicals were used as such without any further purification.
Preparation of aqueous extract
Desmodium gangeticum (Linn) DC. roots were collected from the botanical garden of St. Berchmans College, Changanassery, Kerala, India and authenticated by HOD, Botony department, SB college. The voucher of the specimen was kept for reference. The collected roots were washed thrice thoroughly with tap water and dried in the shade. Roots were cut into small pieces and grinded coarsely using pulveriser. Soxhelt extraction was carried out to obtain crude aqueous extract. The obtained sample is vapourized and lyophilized for the further purpose.
Synthesis of Ni nanoparticles
Ni nanoparticles were synthesized by the simple reduction method. NiCl2 solution and crude aqueous DG extract was mixed in three different ratio, 1:2, 1:5 and 1:10. The mixture was heated at 80 °C under thorough stirring for around 45 min till the colour of the solution turns from brown to grey. Thus prepared nanoparticles were dried, ground well and obtained the fine powder and were stored for further analysis.
Characterization of Ni nanoparticles
Ni nanoparticles were analysed for its characteristic maximum wavelength (λ) using UV visible spectrophotometer. The absorbance was read out in a wide range of wavelength from 200 nm and 800 nm for the synthesized nanoparticles. FTIR analysis was done to determine the chemical entities and functional groups involved during the synthesis procedure The spectrum was recorded (Perkin Elmer spectrum1) between 4000 and 400 cm-1 with a resolution of 4 cm-1. Crystallinity nature of the synthesized nanoparticles was studied using X-ray diffractometry (XRD (Ultima IV, Rigaku). Average size and phase purity were determined. XRD pattern was recorded in a wide range of Bragg’s angles 2θ from 10° to 80° at a scanning rate of 2° min−1. The size and morphology of Ni nanoparticles were studied using scanning electron microscope (SEM) (JEOL-JSM 7601F, Japan). The micrographs of nanoparticles were analysed with “ImageJ 1.34s” software. Preparation of stable nanoparticles has become the significant demand in the current research interest. To determine the thermal stability of the nanoparticles and to study about the behaviour of the stabilizing molecules, thermogravimetric (TGA) analysis was performed using SDT-Q600 model, TA instrument USA. Analysis was carried out under nitrogen atmosphere at a heating rate of 10 °C/min and thermogram was recorded between 40 °C and 1000 °C.
Free radical scavenging, total phenol and reducing power assay
The free radical scavenging effect of DG extract and nickel nanoparticles on DPPH free radical was carried out according to Solver-Rivas et al. (2000) with slight modification [31]. Total phenol was measured by the Folin-Ciocalteau reagent in alkaline medium [32]. Reducing potential of biosynthesized nickel nanoparticles and DG extract was determined by Oyaizu method [33].
Antimicrobial activity
Antibacterial activity of the Ni nanoparticles was determined using agar well diffusion method [34]. 25 mL of molten and cooled Muller-Hintor agar were poured in sterilized petri plates. The plates were left overnight at room temperature to check for any contamination. All the bacterial test organisms (Bacillus subtilis MTCC-2413, Escherichia coli MTCC-574 and Staphylococcus aureus E1 Env. Isolate 3) were grown in nutrient broth for 24 hr. A 100 μl nutrient broth cultures of each bacterial organism were used to prepare bacterial lawns in petri plates. Agar wells were prepared with the help of a sterilized stainless steel cork borer. The wells in each plate were loaded with 100 μl of Ni nanoparticles, precursor (NiCl₂) and aqueous DG extract. Ciprofloxaxin (1 mg/ml) was used as control. The inoculated plates were incubated at 25 °C and checked for the zone of inhibition.
Toxicology
Cytotoxicity of Ni nanoparticle was determined by Lactate dehydrogenase activity (LDH) in the culture medium. This assay determines the release of cytoplasmic enzyme lactate dehydrogenase from the plasma membrane to the culture media due to its leakage from the damaged cells due to the presence of the nanoparticles. Cells were seeded in 96 well plates and were treated with synthesised Ni nanoparticle, along with precursor (NiCl₂). LLC PK1 cell lines were used. After 48 hours of treatment, small aliquot of the medium was collected and incubated with reaction mixture containing NAD+, lactate and phosphate buffer, each 50 µl. The LDH catalyzed conversion results in the reduction of the tetrazolium salt to Formosan (NAD+to NADH) which was measured at an absorbance of 340 nm.
The LDH activity was calculated by the formula
 ---Eqn 3
---Eqn 3
Where AT is the absorbance at time “T”
Statistics
Data of DPPH, reducing power, total phenol and LDH assay signify the mean±SD of three samples and are representatives of three independent experiments. The data were subjected to an analysis of variance (ANOVA) by Graphpad prism 5.
RESULTS AND DISCUSSION
We prepared less aggregate and stable Ni nanoparticles biogenetically by using the aqueous extract of DG root with spherical shape and with an average size around 23 nm and were stable. The Ni nanoparticles exhibited antimicrobial effect and has high reducing potential and free radical scavenging ability.
Characterization of Ni nanoparticles UV
Synthesis of Ni nanoparticle with DG extract was physically verified by the colour change from green to dark brown. The absorption behaviour of Ni nanoparticles was studied using UV–Vis spectrophotometer. From the observed spectral shift in the absorption band nanoparticles formation was confirmed. Fig. 1A shows the spectral band of Ni nanoparticles with maximum lambda at 270 nm. This is due to characteristic surface plasmon resonance effect. On decreasing the concentration of DG extracts, the maximum absorption band spectrum shift from 380 nm to 270 nm that may be due to the less aggregation of the particles size confinement. Shape of the nanoparticles was found to be spherical and was monodispersed.
XRD
X-ray diffraction analysis was used to identify the phase and crystallinity of nanoparticles. The XRD pattern of Ni nanoparticles is shown in fig. 1B. A sharp diffraction peak emerges at 2θ angles of 44.5°, 51.8° and 76.4° corresponds to [111], [200] and [220] crystal planes respectively which are in good agreement with face centred cubical structure of Ni nanoparticles [21]. The pattern is in accordance with JCPDS file (card number 04-0835). The peaks at 20.41° and 33.47° correspond to the reflections from [001] and [100] crystal planes exhibits cubical structure of Ni(OH)2 particles [35]. The peak at 36.71° corresponds to [311] plane corresponds to NiO nanoparticle (JCPDS file card number 04-0850) [36]. The particle size estimated based on the Debye-Scherrer equation was 0.5 nm.
FTIR
The interaction between different species and changes in chemical composition of the mixture was investigated by FTIR. Fig. 1C and 1D shows the IR spectra of Ni nanoparticles and DG extract recorded in the range of 400 – 4000 cm-1. The IR spectrum of Ni nanoparticles covers an absorption band at 3222.90 cm-1, 2075.26 cm-1, 1633.70 cm-1, 1403.88 cm-1, 1104.96 cm-1 and 673.07 cm-1(fig. 1C) and the DG extract at 3746.92 cm-1, 3404.83 cm-1, 2928.63 cm-1, 2114.53 cm-1, 1622.95 cm-1, 1400 cm-1, 1079.11 cm-1, 1027.21 cm-1 and 671.49 cm-1 (fig. 1D). It is found that the absorption peaks of Ni nanoparticles at 3222.90 cm-1, 1633.70 cm-1, 1403.88 cm-1 and 673.07 cm-1corresponds to the absorption peaks that are obtained for DG extract. Strong absorption peak at 3222.90 cm-1, 1633.70 cm-1, 1403.88 cm-1, 1104.96 cm-1 and 673.07 cm-1refers to O-H stretching, cross linked C-C stretching, stretching vibration of C=O group, C-O stretching and C-Cl stretching, respectively [37]. The above result implies that there is interaction between nanoparticles and aqueous DG extract and further evaluated by TGA.
Thermo gravimetric analysis
The existence of physicochemical moisture either in the form of physical adsorption or in the chemically bound hydroxyl group was analysed by thermo gravimetric technique and the thermo-gram is shown in fig. 2. DG extract showed a linear weight loss till 700 °C (fig. 2B). However, bound onto the Ni nanoparticle surface, DG extract exhibits a delayed decomposition. At 700 °C, DG extract showed 65% weight loss while Ni nanoparticles showed 40% weight loss. Three significant decays are observed which are of about 11.8%, 16.82% and 30.64% in the range 90-180 °C, 310-650 °C and 680-780 °C. The weight loss around 100 °C corresponds to the evaporation of water molecules and organic compounds. A weight loss at 160 °C is observed due to the evaporation of triterpene-β amyrone, a phytoconstituent reported in DG extract [38]. The decay at 170 °C corresponds to Stigmasterol, a major sterol constituent in DG extract [39]. Another decay of the component was found at the range between 297 to 298 °C which may be the decay of isoflavone, Genistein [30]. A weight loss observed at 316 °C corresponds to quercetin, 7-O-β-D-glucopyranoside of DG extract. Further IR spectrum corresponds to Ni nanoparticles (fig 1C). The results thus indicate that there is a strong interaction between DG extract and Ni nanoparticles.

Fig. 1: Characterization of Ni nanoparticles by UV-Visible spectrophotometry, X-Ray Diffractometry and Fourier Transform Infrared Spectroscopy (1A) UV-Visible spectrum of three concentrations of Ni nanoparticles was measured at a range of 300-800 nm. The maximum lamba at 270 nm was observed for ‘c’ which is in 1:2 ratio concentration; (1B) X-Ray Diffractometry of Ni nanoparticles were measured and showed different peaks at 2θ angles of 44.5°, 51.8°, 76.4°, 20.41°, 33.47° and 36.71° corresponding to the hkl values from 111, 200, 220, 001, 100 and 311 (Rigako instrument); (1C) Fourier Transform Infrared Spectroscopy of Ni nanoparticles were measured between 400 – 4000 cm-1showed peaks at 3222.90 cm-1, 2075.26 cm-1, 1633.70 cm-1, 1403.88 cm-1, 1104.96 cm-1 and 673.07 cm-1 (Perkin Elmer spectrum1); (1D) Fourier Transform Infrared Spectroscopy of Desmodium gangeticum root extracts were measured between 400 – 4000 cm-1showed peaks at 3746.92 cm-1, 3404.83 cm-1, 2928.63 cm-1, 2114.53 cm-1, 1622.95 cm-1, 1400 cm-1, 1079.11 cm-1, 1027.21 cm-1 and 671.49 cm-1 (Perkin Elmer spectrum1)

Fig. 2: Thermo Gravimetric Analysis of Ni nanoparticle and Desmodium gangeticum root extracts (SDT-Q600 model, TA instrument USA) (2A) Thermo Gravimetric Analysis of Ni nanoparticle showed multiple stage decomposition of about 11.8%, 16.82% and 30.64%; (2B) Thermo Gravimetric Analysis of DG extract showed 80% of its biomolecules decomposed between 80°C-600°C
SEM
Scanning electron microscopy was used to characterize the mean particle size and morphology of Ni nanoparticle. The analysis of Ni nanoparticle showed less aggregated spherical shaped nanoparticles with a size range from 20 to 30 nm in diameter with a range of 22 nm to 25 nm (fig. 3). Scanning Electron Micrograph (JEOL-JSM 7601F, Japan) shows even distribution of nanoparticles with an average size of around 23 nm and also spherical morphology of the synthesized Ni nanoparticles could be observed with less aggregation.

Fig. 3: Scanning Electron Micrograph of Ni nanoparticles
DPPH, Total phenol determination and Reducing potential
Free radical scavenging activity is determined by the capability to scavenge free radical. From fig. 4, gradual decrease in the scavenging activity with the decline in concentration of Ni nanoparticle can be seen. The antioxidant activity of Ni nanoparticles was significantly high as compared its precursor (NiCl2) but lower than the aqueous DG extract.
Total phenolic content was determined by the spectrophotometric method using Folin-Ciocalteu reagent and the results are shown in fig. 5A. The phenolic concentration of Ni nanoparticles was found to be 2.031 mg/ml and for aqueous DG root extract it was 1.945 mg/ml. In fact both Ni nanoparticle and DG extract showed relatively same reduction potential (fig. 5B) and predict, high antioxidant potential which was reflected in DPPH results (fig. 4). The DPPH activity was calculated by.
% Scavenging = 

Fig. 4: DPPH Scavenging Activity
DPPH scavenging activity of Ni nanoparticles at various concentrations (1 to 0.03125 mg/ml) and the precursors (NiCl2 and Desmodium gangeticum root extract) for 1 mg/ml concentration were expressed in percentage activity as shown in the graph.

Fig. 5: Total Phenol determination and Reducing potential
(5A) Total phenolic content for Ni nanoparticle (NP) and Desmodium gangeticum (DG) root extract was expressed in the terms of concentration (mg/ml). The results were expressed as mean±SD of n = 4-6 independent assays, p<0.05, statistically different from the Desmodium gangeticum root extract; (5B) Reducing potential of precursors NiCl2 and Desmodium gangeticum (DG) root extract and the Ni nanoparticle were shown in graph in terms of percentage activity of reducing power.
.
Fig. 6: Antimicrobial assay – Well diffusion method
Antimicrobial activity
Agar well diffusion method was used to determine the antimicrobial activity of Ni nanoparticle against Gram positive (Bacillus subtilis and Staphylococcus aureus E1) and Gram negative (Escherichia coli) bacteria. The zone of inhibition was measured in the incubated petri plates using the software J (National Institutes of Health) and the values are tabulated and shown in the fig. 6. It is seen that the Ni nanoparticles have more effect against Staphylococcus aureus E1, followed by Escherichia coli. However, compared to the precursor NiCl2, Ni nanoparticles showed less antimicrobial activity. On the other hand, the nanoparticle showed notable activity when compared to the aqueous DG extracts and the control. This may be due to the smaller size and high surface to volume ratio of the Ni nanoparticles which gets incorporated into the cell membrane and cause damage to the bacteria and eventually leads to death. The above fig. illustrates zone of inhibition of three different strains for Ni nanoparticles, precursors (NiCl2 and Desmodium gangeticum (DG) root extract) and the control ciprofloxaxin. 6A) Bacillus subtilis; 6B) Escherichia coli; 6C) Staphylococcus aureus E1. The zones were measured using “ImageJ 1.34s” software.
Table 1: Antimicrobial activity (Zone of inhibition)
| Strains | Ni NP (in mm) |
Control (in mm) | DG extract (in mm) |
NiCl₂ (in mm) |
| Bacillus subtilis (MTCC-2413) | 17.831 | 16.638 | 11.488 | 33.282 |
| Escherichia coli (MTCC-574) | 23.121 | 18.343 | 10.407 | 36.901 |
| Staphylococcus aureus E1 | 25.254 | 17.669 | 10.038 | 22.954 |
The table depicted the zone of measurement of antimicrobial activity for strains Bacillus subtilis, Escherichia coli, Staphylococcus aureus E1 for Ni nanoparticles, precursors (NiCl2 and Desmodium gangeticum (DG) root extract) and the control ciprofloxaxin.
Toxicology
Fig. 7 shows the activity of released lactate dehydrogenase in cell culture medium upon incubation of LLC PK1 with Ni nanoparticle. The results suggests that Ni nanoparticle has less toxic effect than its precursors DG extract or NiCl₂. The interaction between phytomolecules and Ni ions reduces the toxicity caused by precursor, NiCl₂. Thus the synthesized nanoparticles are found to be safe for further medical applications.

*Thevaluesarerepresentedasmean±SD, n=3
Fig.7: Cellular damage-LDH activity
Fig. 7: shows LDH leakage in the cell culture medium after treated with Ni nanoparticles and it’s precursors, NiCl2 and Desmodium gangeticum root extract. Ni nanoparticle had less activity on cell lines than the precursors. The result was expressed as mean±SD of n = 4-6 independent assays, p<0.05, statistically different from the normal control group (no treatments were made).
CONCLUSION
In summary, we provided a novel cost effective green approach for the synthesis of Ni nanoparticle using Desmodium gangeticum aqueous root extract. We prepared stable nanoparticle aggregates with spherical geometry and size of around 23 nm. The synthesised nanoparticle is safe for the use as it did not show any significant cytotoxicity in LLC PK1 epithelial cells. Further the presence of phenolic content and the resultant reducing property not only render antioxidant property but also makes it good antimicrobial agent.
ACKNOWLEDGEMENT
We are greatly acknowledged to SASTRA University for their financial supports and research facilities. Dr. P. Brindha, Dean, Centre for Advanced Research in Indian System of Medicine (CARISM), SASTRA University for her support and critical comments are highly acknowledged.
CONFLICT OF INTERESTS
Declared None
REFERENCES
- Horcajada P, Chalati T, Serre C, Gillet B, Sebrie C, Baati T, et al. Porous metal-organic-framework nanoscale carriers as a potential platform for drug delivery and imaging. Nat Mater 2009;9(2):172-8.
- Sellers K, Mackay C, Bergeson LL, Clough SR, Hoyt M, Chen J, et al. Nanotechnology and the Environment: Crc Press; 2008.
- Murthy SK. Nanoparticles in modern medicine: state of the art and future challenges. Int J Nanomed 2007;2(2):129.
- Bodor M, Santos RM, Chiang YW, Vlad M, Van T. In Utilization of nickel nanoparticles as a catalytic additive for mineral carbonation process acceleration, New Trends in Environmental and Materials Engineering, Galati, Romania, 28-30 October KU Leuven publication: Galati, Romania.
- Lok J, Geim A, Maan J, Dubonos S, Kuhn LT, Lindelof P. Memory effects in individual submicrometer ferromagnets. Physical Rev B 1998;58(18):12201.
- Wang SF, Xie F, Hu RF. Carbon-coated nickel magnetic nanoparticles modified electrodes as a sensor for determination of acetaminophen. Sensors Actuators B: Chem 2007;123(1):495-500.
- Tseng WJ, Chen CN. Dispersion and rheology of nickel nanoparticle inks. J Mater Sci 2006;41(4):1213-9.
- Rinaldi C, Franklin T, Zahn M, Cader T. Magnetic nanoparticles in fluid suspension: ferrofluid applications. Encyclopedia of Nanoscience and Nanotechnology; 2004. p. 1.
- Yao Y, Chen Y, Tai M, Wang D, Lin H. Magnetic anisotropy effects in nano-cluster nickel particles. Mater Sci Eng: A 1996;217:281-5.
- Zach MP, Penner RM. Nanocrystalline nickel nanoparticles. Adv Mater 2000;12(12):878-83.
- Hou Y, Kondoh H, Ohta T. Magnetic Properties and Fabrication of Monodisperse FePd Nanoparticles. Nanoparticles and Nanowire Building Blocks--Synthesis, Processing, Characterization and Theory; 2004. p. 23-7.
- Kumar RV, Koltypin Y, Palchik O, Gedanken A. Preparation and characterization of nickel–polystyrene nanocomposite by ultrasound irradiation. J Appl Polym Sci 2002;86(1):160-5.
- Stopic S, Nedeljkovic J, Rakocevic Z, Uskokovic D. Influence of additives on the properties of spherical nickel particles prepared by ultrasonic spray pyrolysis. J Mater Res 1999;14:3059-65.
- Carroll KJ, Reveles JU, Shultz MD, Khanna SN, Carpenter EE. Preparation of elemental Cu and Ni nanoparticles by the polyol method: an experimental and theoretical approach. J Phys Chem C 2011;115(6):2656-64.
- Zhang H, Wu G, Chen X, Qiu X. Synthesis and magnetic properties of nickel nanocrystals. Mater Res Bull 2006;41(3):495-501.
- Ma S, Srikanth V, Maik D, Zhang G, Staedler T, Jiang X. From carbon nanobells to nickel nanotubes. Appl Phys Lett 2009;94(1):13109-13109-3.
- Jaleh B, Omidvar Dezfuli A, Jaberian Hamedan V, Najafi M, Tamari E. Preparation of nickel nanowire within polycarbonate membrane and removing polycarbonate by KrF excimer laser. Int J Phys Sci 2011;6:4775-80.
- Ni XM, Su XB, Yang ZP, Zheng HG. The preparation of nickel nanorods in water-in-oil microemulsion. J Cryst Growth 2003;252(4):612-7.
- Zhang HL, Li F, Liu C, Cheng HM. The facile synthesis of nickel silicide nanobelts and nanosheets and their application in electrochemical energy storage. Nanotechnol 2008;19(16):165606.
- Khanna P, More PV, Jawalkar JP, Bharate B. Effect of reducing agent on the synthesis of nickel nanoparticles. Mater Lett 2009;63(16):1384-6.
- Wu X, Xing W, Zhang L, Zhuo S, Zhou J, Wang G, et al. Nickel nanoparticles prepared by hydrazine hydrate reduction and their application in supercapacitor. Powder Technol 2012;224:162-7.
- Kurian GA, Yagnesh N, Kishan RS, Paddikkala J. Methanol extract of Desmodium gangeticum roots preserves mitochondrial respiratory enzymes, protecting rat heart against oxidative stress induced by reperfusion injury. J Pharm Pharmacol 2008;60(4):523-30.
- Rathi A, Rao CV, Ravishankar B, De S, Mehrotra S. Anti-inflammatory and anti-nociceptive activity of the water decoction Desmodium gangeticum. J Ethnopharmacol 2004;95(2):259-63.
- Jabbar S, Khan M, Choudhuri M. The effects of aqueous extracts of Desmodium gangeticum DC.(Leguminosae) on the central nervous system. Pharm 2001;56(6):506-8.
- Kurian GA, Suryanarayanan S, Raman A, Padikkala J. Antioxidant effects of ethyl acetate extract of Desmodium gangeticum root on myocardial ischemia reperfusion injury in rat hearts. Chin Med 2010;5(1):3.
- Kirtikar KR, Basu BD. Indian medicinal plants. indian medicinal plants; 1918.
- Kurian GA, Paddikkala J. Administration of aqueous extract of Desmodium gangeticum (L) root protects rat heart against ischemic reperfusion injury induced oxidative stress. Indian J Exp Biol 2009:47;129-35.
- Kurian GA, Philip S, Varghese T. Effect of aqueous extract of the Desmodium gangeticum DC root in the severity of myocardial infarction. J Ethnopharmacol 2005;97(3):457-46.
- Ahmad N, Sharma S, Singh V, Shamsi S, Fatma A, Mehta B. Biosynthesis of silver nanoparticles from Desmodium triflorum: a novel approach towards weed utilization. Biotechnol Res Int 2010, 2011.
- Mishra PK, Singh N, Ahmad G, Dube A, Maurya R. Glycolipids and other constituents from Desmodium gangeticum with antileishmanial and immunomodulatory activities. Bioorg Med Chem Lett 2005;15(20):4543-6.
- Jayachitra A, Krithiga N. Study on antioxidant property in selected medicinal plant extracts. Int J Med Aromatic Plants 2012;2(3):495-500.
- Rice-Evans C, Miller N, Paganga G. Antioxidant properties of phenolic compounds. Trends Plant Sci 1997;2(4):152-9.
- Huo L, Lu R, Li P, Liao Y, Chen R, Deng C, et al. Antioxidant activity, total phenolic, and total flavonoid of extracts from stems of Jasminum nervosum Lour. Grasas y Aceites 2011;62(2):149-54.
- Harish K, Renu R, Kumar SR. Synthesis of nickel hydroxide nanoparticles by reverse micelle method and its antimicrobial activity. Res J Chem Sci 2011;1:42-8.
- Li J, Yang M, Wei J, Zhou Z. Preparation and electrochemical performances of doughnut-like Ni (OH) 2–Co (OH) 2 composites as pseudocapacitor materials. Nanoscale 2012;4(15):4498-503.
- Shah M. A versatile route for the synthesis of nickel oxide nanostructures without organics at low temperature. Nanoscale Res Lett 2008;3(7):255-9.
- Coates J. Interpretation of infrared spectra, a practical approach. Encycl Anal Chem 2000:10815-37.
- Kurian GA, Paddikkala J. Methanol extract of Desmodium gangeticum DC root mimetic post-conditioning effect in isolated perfused rat heart by stimulating muscarinic receptors. Asian Pac J Trop Biomed 2012;5(6):448-54.
- Hemlal H, Ravi S. GC-MS, HPTLC and Antimicrobial analysis of Root extracts of Pseudarthria viscida Wight and Arn and Desmodium gangeticum (Linn) DC. Int Res J Biol Sci 2012;1:57-65.